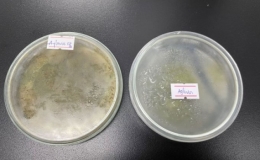

13 nhà khoa học Việt vào bảng xếp hạng thế giới
Trong số 13 nhà khoa học Việt có mặt trong danh sách xếp hạng của Research.com năm nay, lần đầu tiên có một cá nhân ở lĩnh vực xã hội nhân văn.
3 năm trước 2,637 lượt xem

Hơn 120 dự án tham gia cuộc thi Sáng kiến Khoa học 2023
Cuộc thi Sáng kiến Khoa học do VnExpress tổ chức đóng cổng nhận hồ sơ từ 12h ngày 10/3 sau hơn 2 tháng phát động, nhận được hơn 120 hồ sơ tham dự.
3 năm trước 2,676 lượt xem

Turbine gió nổi đầu tiên trên thế giới
Giàn turbine gió nổi đầu tiên trên thế giới được phát triển bởi X1 Wind, được lắp đặt ở quần đảo Canary (Tây Ban Nha) với hệ thống neo sâu dưới đáy biển.
3 năm trước 1,769 lượt xem

Trạm ISS kích hoạt động cơ để bay tránh vệ tinh
Khoảng 19h42 hôm 6/3, Trạm Vũ trụ Quốc tế (ISS) phải chỉnh hướng để tránh khỏi đường bay của một vệ tinh quan sát Trái Đất.
3 năm trước 2,008 lượt xem

'Sản phẩm xuất khẩu tiềm năng sẽ được bảo hộ quyền khai thác ở nước ngoài'
Các sản phẩm xuất khẩu tiềm năng của Việt Nam được bảo hộ nhãn hiệu và chỉ dẫn địa lý ở nước ngoài giúp doanh nghiệp sử dụng hiệu quả tài sản trí tuệ.
3 năm trước 1,383 lượt xem
Nâng cao kiến thức thương mại hóa kết quả nghiên cứu khoa học-công nghệ
Trong 2 ngày 8 và 9/3, tại thành phố Buôn Ma Thuột, tỉnh Đắk Lắk, Ban Quản lý dự án hỗ trợ kỹ thuật Trung tâm đổi mới sáng tạo ứng phó với biến đổi khí...
3 năm trước
1,722 lượt xem
Con người sẽ ra sao nếu hết nhiên liệu hóa thạch?
Các nguồn tài nguyên hữu hạn ngày càng cạn kiệt thúc đẩy con người tìm kiếm những giải pháp năng lượng tái tạo mới để tiếp tục tồn tại.
3 năm trước
2,180 lượt xem
Giáo sư 'sát thủ' của khí thải
Hơn 20 năm, GS.TS Lê Minh Thắng tìm cách phát triển bộ xúc tác hỗn hợp oxit kim loại để xử lý khí thải động cơ, giảm tới hơn 90% lượng khí ô nhiễm.
3 năm trước
1,862 lượt xem
Máy bay vận tải lớn nhất thế giới cất cánh trên bầu trời ảo
Một năm sau khi bị phá hủy, máy bay vận tải lớn nhất thế giới Antonov AN-225, cất cánh lần nữa trong chương trình mô phỏng bay của Microsoft.
3 năm trước
1,422 lượt xem
Sinh viên dùng CO2 hãm phát triển nấm mốc trên lúa
Nấm mốc trên lúa gạo sinh độc tố gây ung thư được nhóm sinh viên ĐH Công nghiệp Thực phẩm TP HCM nghiên cứu sử dụng CO2 ức chế sinh trưởng.
3 năm trước
1,774 lượt xem
Tiến sĩ nghiên cứu thuốc được vinh danh gương mặt trẻ Việt Nam tiêu biểu
TS Trương Thanh Tùng được vinh danh thuộc lĩnh vực nghiên cứu khoa học - sáng tạo với nhiều công trình nghiên cứu về thuốc điều trị HIV, ung thư.
3 năm trước
2,170 lượt xem
NASA công bố kết quả thử nghiệm ngăn tiểu hành tinh đâm vào Trái Đất
Trong thử nghiệm ngày 26/9/2022, tàu vũ trụ DART đã đâm vào Dimorphos, một tiểu hành tinh đường kính 150m, cách Trái Đất khoảng 11 triệu km, với tốc độ...
3 năm trước
1,998 lượt xem
Iran lên kế hoạch phóng hai vệ tinh tự sản xuất vào cuối năm
Các vệ tinh dân sự mang tên Kowsar và Hodhod, do các một nhóm các công ty nghiên cứu công nghệ của Iran sản xuất, sẽ được đưa lên quỹ đạo cách bề mặt Trái...
3 năm trước
1,576 lượt xem
Những chiếc tàu ngầm lớn nhất thế giới
Tàu ngầm lớp Belgorod của Nga có chiều dài kỷ lục 184 m nhưng nếu xét về lượng choán nước, nó vẫn nhỏ hơn tàu ngầm lớp Typhoon.
3 năm trước
2,442 lượt xem
Độc đáo tàu hai đầu lớn nhất thế giới
Tàu hai đầu lớn nhất thế giới với chiều dài hơn 230m, cả phần đầu và đuôi đều có buồng lái cho phép điều hướng hai chiều.
3 năm trước
2,250 lượt xem